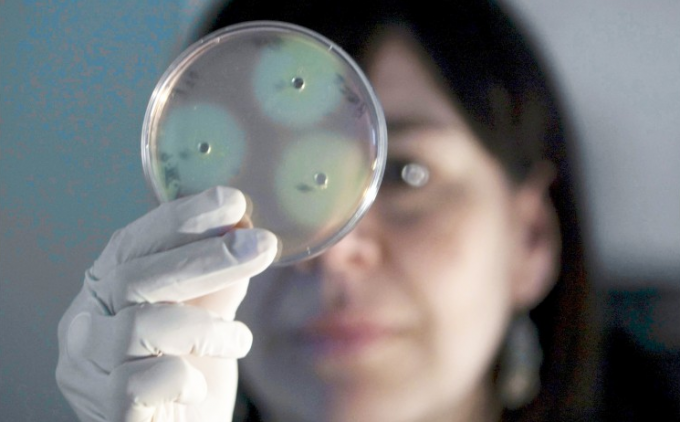

Cambio climático causarÃÂa hongos en humanos
Las enfermedades fúngicas ha devastado muchas especies animales y vegetales, y hasta ahora los humanos y otros mamíferos parecían estar protegidos por su temperatura corporal; sin embargo, científicos advierten que el cambio climático podría desafiar esa defensa.
Un estudio realizado por microbiólogos estadunidenses reveló que el cambio climático puede traer nuevas amenazas de hongos a la salud humana, pues éstos podrían estar volviéndose tolerantes a la temperatura corporal promedio de las personas y, gracias a ello, multiplicándose.
Los investigadores refieren que entre 2012 y 2015 surgieron versiones patógenas del hongo Candida auris de manera independiente en África, Asia y América del Sur, las cuales son de la misma especie, pero genéticamente distintas, por lo que descartaron su propagación a través de los continentes por viajeros infectados.
El Candida auris de cada continente pudo haberse vuelto tolerante a la temperatura corporal normal promedio de las personas, alrededor de 36 grados centígrados (°C), afirman los investigadores en un artículo publicado mBio, revista de la Sociedad Americana de Microbiología.
Explican que los hongos se habrían aclimatado al calentamiento global y “si esta hipótesis resulta cierta, C. auris podría ser el primer ejemplo de una nueva enfermedad micótica derivada del cambio climático que plantea un riesgo para los humanos”, enfatizan los microbiólogos.
El informe de la investigación refiere que desde mediados de 2016 comenzaron a registrarse infecciones por C. auris en Estados Unidos y hasta ahora se han confirmado casi 700 casos en 12 estados del país, con brotes mortales entre pacientes en hospitales y otras instalaciones de atención médica.
Más de 30 países alrededor del mundo también han reportado casos de este hongo, que causa infecciones peligrosas en la sangre, el cerebro, el corazón y otras partes del cuerpo.
Los estudios muestran que una infección invasiva puede ser mortal del 30 al 60 por ciento de las veces, mientras que algunas infecciones son resistentes a todos los medicamentos antimicóticos disponibles.
Los científicos señalan que los pacientes hospitalizados tienden a tener sistemas inmunitarios debilitados, pero advierten que el C. auris no sería un problema de salud si no hubiera desarrollado primero la capacidad de replicarse dentro de las personas y para ello debió hacerse más tolerante a temperaturas más cálidas.
“A medida que se adapten a un clima más cálido, algunos de ellos (hongos) tendrán la capacidad de romper nuestras defensas térmicas”, advierten.
RECOMENDADAS
Impulsa SS la sensibilización de donación y trasplante de órganos
no todas las personas son candidatas a donar


























 MARQUESINA POLITICA
MARQUESINA POLITICA KIOSCO MAYOR
KIOSCO MAYOR ECOS DE LA NOTICIA
ECOS DE LA NOTICIA CANAL SONORA
CANAL SONORA CENTRAL INFORMATIVA
CENTRAL INFORMATIVA SONORA HOY
SONORA HOY DOSSIER POLITICO
DOSSIER POLITICO SONORA NEWS
SONORA NEWS ENTRE GRILLOS Y CHAPULINES
ENTRE GRILLOS Y CHAPULINES  SEMANARIO DESIERTO
SEMANARIO DESIERTO RADIO LOBO
RADIO LOBO EL PORTAL DE LA GENTE
EL PORTAL DE LA GENTE